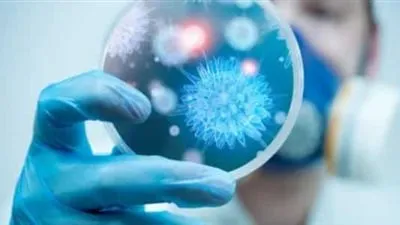
تسجيل أول إصابتين بـ

عاجل
بث مباشر الآن مباراة الأهلي والمقاولون العرب في الدوري المصري.. المارد الأحمر يصطدم بذئاب الجبل في مواجهة مشتعلة
بث مباشر الآن.. الأهلي يواجه المقاولون العرب في ليلة البحث عن الانتصار بالدوري المصري
بث مباشر مباراة الأهلي والمقاولون العرب اليوم في الدوري المصري.. صدام قوي بين المارد الأحمر وذئاب الجبل
مصطفى كامل يكشف تفاصيل أزمة هاني مهنا وإيقافه عن الظهور الإعلامي
الفنانة الجزائرية مريم حليم: تجربة "الحلم" عززت مكانتي الفنية في الوسط المصري